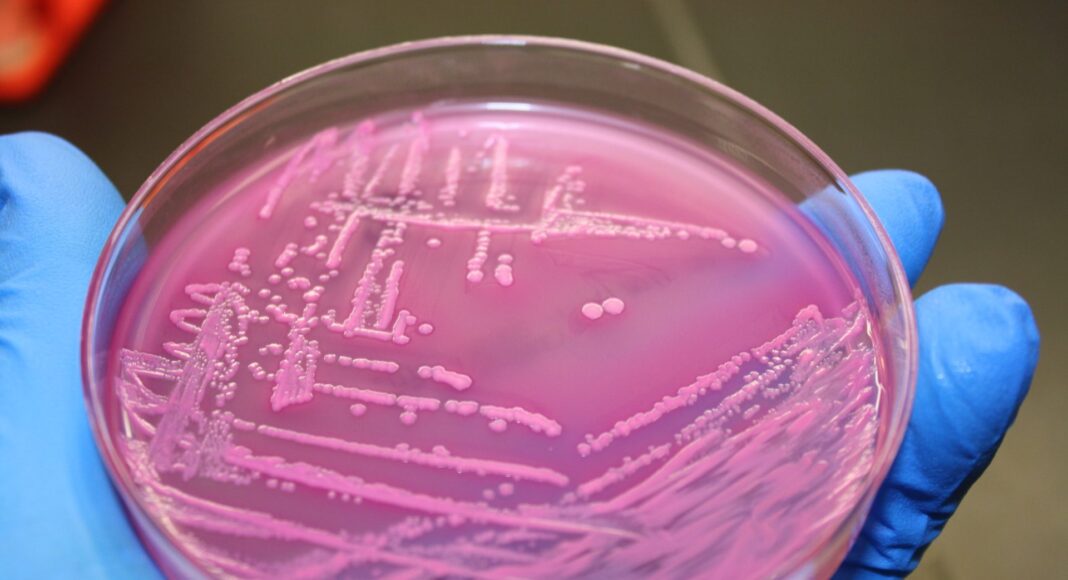

Το κολοβακτηρίδιο ή E. coli (Escherichia coli), ένα βακτήριο που ζει φυσιολογικά στο ανθρώπινο έντερο, μπορεί να εξαπλώνεται στους πληθυσμούς με ρυθμό συγκρίσιμο με εκείνον του ιού της γρίπης των χοίρων, σύμφωνα με νέα μελέτη. Για πρώτη φορά, ερευνητές από το Wellcome Sanger Institute στη Βρετανία, σε συνεργασία με τα Πανεπιστήμια του Όσλο, του Ελσίνκι και το Aalto στη Φινλανδία, κατόρθωσαν να υπολογίσουν πόσο αποτελεσματικά μπορούν τα εντερικά βακτήρια να μεταδoθούν από άνθρωπο σε άνθρωπο.
Το E. coli είναι μια από τις κύριες αιτίες λοιμώξεων παγκοσμίως. Αν και τα περισσότερα στελέχη του είναι ακίνδυνα και ζουν φυσιολογικά στο έντερο, το βακτήριο μπορεί να περάσει στο σώμα μέσω άμεσης επαφής (όπως το φιλί) ή έμμεσων τρόπων (όπως κοινές επιφάνειες, τρόφιμα ή χώρους διαβίωσης). Όταν εισέρχεται στο ουροποιητικό σύστημα, μπορεί να προκαλέσει σοβαρές λοιμώξεις, ακόμη και σηψαιμία, ιδιαίτερα σε άτομα με εξασθενημένο ανοσοποιητικό σύστημα.
Εντοπισμός επικίνδυνων στελεχών στους πληθυσμούς
Η μελέτη, που δημοσιεύθηκε στο επιστημονικό περιοδικό Nature Communications, εξέτασε τρία βασικά στελέχη του E. coli που κυκλοφορούν στο Ηνωμένο Βασίλειο και τη Νορβηγία. Δύο από αυτά είναι ανθεκτικά σε πολλές κατηγορίες κοινών αντιβιοτικών και αποτελούν τις συχνότερες αιτίες λοιμώξεων του ουροποιητικού και του αίματος στις δύο χώρες.
Οι ερευνητές επισημαίνουν ότι η καλύτερη παρακολούθηση αυτών των στελεχών θα μπορούσε να καθοδηγήσει τη δημόσια υγεία και να αποτρέψει επιδημίες δύσκολων στη θεραπεία λοιμώξεων. Σε βάθος χρόνου, η κατανόηση των γενετικών παραγόντων που βοηθούν το E. coli να εξαπλώνεται μπορεί να οδηγήσει σε πιο στοχευμένες θεραπείες και να μειώσει την εξάρτηση από τα ευρέως φάσματος αντιβιοτικά.
Εφαρμόζοντας «ιικά» μοντέλα μετάδοσης στα βακτήρια
Οι επιστήμονες μετρούν τη μεταδοτικότητα ενός παθογόνου μέσω του δείκτη R₀ (βασικός αριθμός αναπαραγωγής) — ενός μέτρου που αποτυπώνει τον ρυθμό εξάπλωσής του και δείχνει πόσα άτομα μπορεί να μολύνει ένας φορέας. Μέχρι σήμερα, ο δείκτης αυτός χρησιμοποιούνταν κυρίως για ιούς, καθώς τα βακτήρια του εντέρου συνήθως ζουν στο σώμα χωρίς να προκαλούν νόσο.
Για να ξεπεράσουν αυτό το εμπόδιο, οι ερευνητές συνδύασαν δεδομένα από τη μελέτη UK Baby Biome με γενετικές πληροφορίες από προγράμματα επιτήρησης λοιμώξεων αίματος από E. coli στο Ηνωμένο Βασίλειο και τη Νορβηγία. Με τη βοήθεια της πλατφόρμας ELFI3 (Engine for Likelihood-Free Inference), ανέπτυξαν ένα νέο μοντέλο ικανό να εκτιμήσει το R₀ για τρία κύρια στελέχη του E. coli. Τα αποτελέσματα έδειξαν ότι ένα συγκεκριμένο στέλεχος, το ST131-A, μπορεί να εξαπλωθεί μεταξύ ανθρώπων με ρυθμό συγκρίσιμο με εκείνον ιών που προκάλεσαν παγκόσμιες επιδημίες, όπως η γρίπη των χοίρων (H1N1) — παρότι το συγκεκριμένο βακτήριο δεν μεταδίδεται μέσω αεροσταγονιδίων.
Τα άλλα δύο στελέχη, ST131-C1 και ST131-C2, αν και ανθεκτικά σε πολλαπλά αντιβιοτικά, εξαπλώνονται πιο αργά μεταξύ υγιών ατόμων. Ωστόσο, σε νοσοκομεία και άλλες δομές υγείας, όπου οι ασθενείς είναι πιο ευάλωτοι, η μετάδοσή τους μπορεί να είναι πολύ ταχύτερη.
Η σημασία του δείκτη R₀ για τα βακτήρια
Ο καθορισμός ενός δείκτη R₀ για βακτήρια ανοίγει τον δρόμο για βαθύτερη κατανόηση της εξάπλωσης των βακτηριακών λοιμώξεων. Επιτρέπει τον εντοπισμό των πιο επικίνδυνων στελεχών και τη βελτίωση των στρατηγικών δημόσιας υγείας.
«Το E. coli είναι από τα πρώτα βακτήρια που αποικίζουν το έντερο ενός βρέφους. Για να κατανοήσουμε πώς τα βακτήριά μας διαμορφώνουν την υγεία μας, πρέπει να γνωρίζουμε από πού ξεκινάμε — και γι’ αυτό η μελέτη UK Baby Biome είναι τόσο σημαντική» εξήγησε ο Δρ. Τρέβορ Λόλεϊ από το Wellcome Sanger Institute.
«Η δυνατότητα του υπολογισμού του R₀ για το E. coli μάς επιτρέπει να δούμε με μεγαλύτερη ακρίβεια πώς εξαπλώνονται τα βακτήρια στους πληθυσμούς και να τα συγκρίνουμε με άλλες λοιμώξεις. Τώρα που γνωρίζουμε πόσο γρήγορα εξαπλώνονται ορισμένα στελέχη, είναι κρίσιμο να κατανοήσουμε τους γενετικούς παράγοντες πίσω από αυτή τη συμπεριφορά — κάτι που θα μπορούσε να οδηγήσει σε νέες διαγνωστικές και θεραπευτικές προσεγγίσεις, ιδιαίτερα για τα πολυανθεκτικά βακτήρια» δήλωσε ο καθηγητής Τζούκα Κοράντερ, επικεφαλής της έρευνας.
ΠΗΓΗ: Science Daily